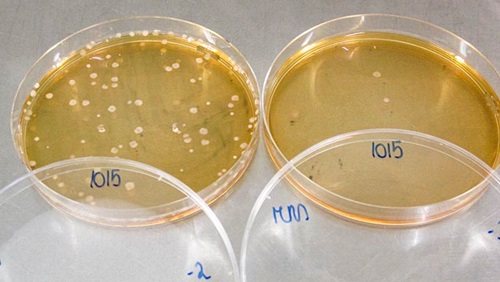

Comment testons-nous les yaourts?


Lors de nos derniers tests, nous avons inclus 19 yaourts natures maigres (maximum 1 % de matière grasse) et 15 alternatives végétales à base de soja, amande, riz, coco, etc., tous affichant un Nutri-Score A ou B. Parmi nos échantillons, des produits étuvés et brassés, mais pas d'aromatisés, de versions « à la grecque » ou comportant de la crème, ni à boire.
Nous avons analysé leur composition, leur goût, leur odeur et leur étiquetage. Nous avons aussi comparé leur prix. Ces analyses ont eu lieu en janvier et février 2022. Les prix ont été relevés en mars 2022.
Comment certains yaourts ont-ils décroché nos labels de qualité ? Pourquoi certains yaourts sont-ils les meilleurs à nos yeux ? Nous vous expliquons dans ce dossier comment nous passons au crible :
- Les étiquettes des 19 yaourts et 15 alternatives végétales;
- Leur composition: présence réelle des ferments lactiques indispensables à l'appellation « yaourt », taux de matière sèche, profil des graisses...
- Et, enfin, leur saveur.
=> Informations obligatoires
Nous vérifions si les informations obligatoires sont bien présentes sur l’étiquette, entre autres :
- La date de péremption
- L’adresse du producteur ou du distributeur
- La liste des ingrédients
- Le poids net
- La valeur nutritionnelle.
Aucun manquement n’a été constaté à ce niveau-là.
=> Informations facultatives
Nous examinons ensuite les informations qui ne sont que facultatives, mais que nous pensons utiles pour faciliter le choix du consommateur au magasin :
- L’origine des ingrédients les plus importants (principalement celle du lait)
- Le pays de production: en l’absence d’une mention claire, il est possible de prendre connaissance de cette information grâce au numéro d’identification européen (EU-n° d’identification)
- Le Nutri-Score ou équivalent sur l’avant du paquet
- Les valeurs nutritionnelles: il serait utile d’indiquer systématiquement les informations nutritionnelles complètes des yaourts sur l’emballage; c’est-à-dire la présence et la quantité exacte des nutriments (notamment celle des fibres qui est toujours facultative); de préférence par portion et par 100g. Le tout représenté de préférence sous forme de tableau
- Le nombre de portions par emballage et une indication de la taille des portions
- Les informations de contact du fabricant (email ou numéro de téléphone)
- La date de production
- Les instructions de conservation après ouverture
- Le type de date de péremption, à côté de la date elle-même
- Une indication qui incite à regarder, sentir et goûter avant de jeter en cas de doute
- La mention du type de yaourt (étuvé ou brassé).
=> Composition
Ferments lactiques
Pour obtenir l’appellation « yaourt », la préparation à base de lait fermenté doit contenir deux bactéries bien spécifiques (également appelées « ferments lactiques »): Lactobacillus bulgaricus et Streptococcus thermophilus. Ces deux bactéries doivent être obligatoirement présentes et vivantes dans le yaourt, à raison d’au moins 10 millions de bactéries par gramme jusqu’à la livraison au consommateur.
Nous procédons à différents tests en labo.
Si on ne retrouve pas ces bactéries dans le produit ou qu’elles ne sont plus vivantes à la suite d’un traitement thermique, il n’est plus considéré comme un « yaourt », mais bien comme un autre type de spécialité laitière.
Lors de nos tests, nous vérifions leur présence lors de la date de péremption. Lorsque les deux bactéries sont présentes en grandes quantités, le produit reçoit un bon score pour ce critère. Si d'autres bactéries sont également mentionnées sur l'étiquette, nous les quantifions et évaluons également.
Profil des acides gras
Le profil des acides gras des alternatives végétales de notre test a été évalué. Plus il y a d'acides gras insaturés, plus leur score est élevé.
Quantité de matière sèche
Nous avons également mesuré la quantité de matière sèche (non grasse) présente dans nos échantillons. La matière sèche est importante puisqu’elle contient notamment les protéines, les sucres, les vitamines, etc.
Nous avons voulu nous assurer que les produits testés en contenaient en suffisance (soit un minimum légal de 8,2 %). Plus la quantité de matière sèche est élevée, meilleur est le score obtenu pour ce paramètre. Cette différence en quantité de matière sèche s’explique par le fait que dans certains yaourts, du lait en poudre (ou des proteines de lait et lactose) est ajouté avant la fermentation pour les rendre plus fermes.
Pour les alternatives végétales, il n'y a pas de minimum légal, les teneurs en matière sèche sont généralement plus faibles que pour les yaourts, nous utilisons donc une échelle de notation moins marquée.
Degré de transformation
Nous avons évalué le degré de transformation des alternatives végétales au yaourt car ces produits peuvent contenir des colorants, des régulateurs d'acidité, des agents épaississants, etc. Qu'est-ce encore qu'un produit ultra-transformé ? Notre dossier vous explique tout:
Les aliments ultra-transformés
Poids net
Nous avons vérifié en laboratoire le poids net des yaourts, mais nous n’avons pas constaté de déficits supérieurs à 1 % (ce qui est en-dessous de la limite légale autorisée).
=> Saveur
Les yaourts ont été soumis à un panel d’experts qui les ont goûtés et notés. Nos goûteurs devaient attribuer un score à chaque yaourt sur les critères du goût et de l’odeur. D’autres aspects tels que l’amertume, la douceur et l’acidité ont également été pris en compte.
Voir les résultats de nos tests

Nos testeurs examinent différents paramètres.

